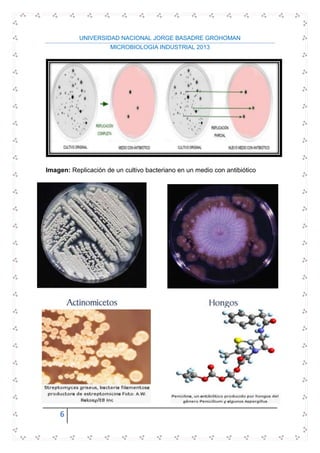
UNIVERSIDAD NACIONAL JORGE BASADRE GROHOMAN
MICROBIOLOGIA INDUSTRIAL 2013
6
Imagen: Replicación de un cultivo bacteriano en un medio con antibiótico

Este documento trata sobre los temas de mejoramiento microbiano a través de la selección natural y la recombinación genética. Explica los procesos de selección natural, transformación, transducción y conjugación que permiten la transferencia de genes entre microorganismos y conducen al desarrollo de cepas con mayor productividad. También incluye ejemplos de organismos que producen antibióticos y una bibliografía relevante.